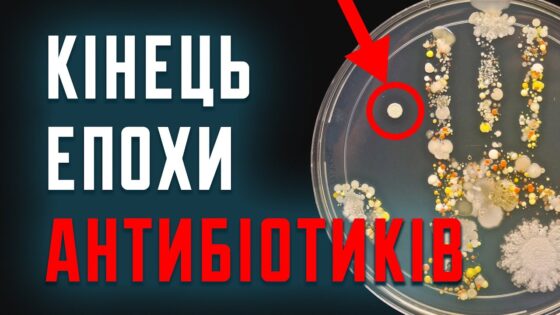

У цьому відео я розповім про тварину, яку більшість із нас знає, але мало хто дійсно добре розуміє.
– Як виглядає хатка бобра зсередини?
– Чому вони витрачають стільки сил на будівництво дамб і як це впливає на навколишню природу?
– Яку користь або шкоду можуть приносити бобри людям?
– Чим харчуються, як живуть і кого бояться?
Усе це — в повному огляді, з цікавими фактами, історичними епізодами та справжніми прикладами з України.
Також поділюсь, як бобри випадково врятували бюджет одного з чеських міст, і чому їх називають “екосистемними інженерами”.
Пиши в коментарях, чи доводилося тобі бачити бобрів на власні очі — або ж, може, вони навіть будували греблю поблизу твого села?
📌 А ще — не забудь зайти в мій Telegram-канал, де зовсім скоро ми разом оберемо героя наступного відео:
https://t.me/encyclopedia_ua
Ось також Instagram:
https://www.instagram.com/encyclope.dia.ua
Підтримати канал можна тут⭐
https://send.monobank.ua/jar/27UJPmmSJt
#бобер #тварини #енциклопедія
Таймкоди:
00:00:00 – Вступ
00:01:09 – Зовнішній вигляд: ідеальний інструментарій природи
00:03:37 – Середовище існування: вода – їхній дім, вода – їхня фортеця
00:06:28 – Поведінка: архітектори, інженери та будівельники 24/7
00:09:18 – Харчування: справжній вегетаріанець з підводною коморою
00:10:35 – Розмноження та тривалість життя: міцні сім’ї та довгожителі водойм
00:12:54 – Еволюція та походження: від гігантів до сучасних майстрів
00:14:12 – Взаємодія з людиною: від хутряної лихоманки до партнерства
00:18:22 – Вороги та захист: коли інженер стає воїном
00:19:45 – Стан популяції та охорона: зниклі, але відроджені
00:21:13 – Цікаві факти: це варто знати!
00:23:46 – Фінал та звернення до глядачів

Будьте першим, хто прокоментує